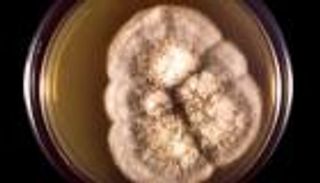
كيف يتسبب التغير المناخي في تنشيط الأمراض الفطرية؟

5 من أمراض الربيع التي يجب الحذر منها.. وطرق الوقاية منها

في فصل الربيع، يصبح الطقس مائلا للدفء ويساعد على نمو النباتات وازدهارها، ولكنه يساهم في نشاط أمراض الربيع التي تحدث نتيجة التحسس وتغيّر الفصول، فماذا نفعل؟
مع الدفء الذي يأتي به فصل الربيع ونمو الأزهار وانتعاش الأرض بعد شتاء قارس وصعب، يصبح "الجو بديع" لكن الكل "مش سعيد"، ويرجع ذلك إلى أمراض الربيع التي تنشط خلال شهوره، ففي حين تحتفل البلاد بالأعياد، تؤثر عملية النمو والازدهار على مرضى الحساسية، بسبب حبوب اللقاح، إلى جانب انتشار أمراض أخرى مزعجة.
أنواع أمراض الربيع
سعادتنا بفصل الربيع والقدرة على تخفيف الملابس والاستمتاع بالجو اللطيف، قد يكدرها الأمراض التي تنتشر خلال هذا الفصل وإغفال الوقاية منها، ولذلك قد تساعدنا المعرفة عن أمراض الربيع على اتخاذ الاحتياطات اللازمة، وأكثرها انتشارا هو:
مرض لايم
هو مرض يُصاب به الشخص عن طريق حشرة القراد التي تنشط في طقس فصل الربيع، خاصة في أوروبا وأمريكا، وتتغذى على الدم، ومن أعراضه الحمى والآلام العضلية والطفح الجلدي والصداع والإرهاق الشديد.
الربو
مع حلول فصل الربيع، تظهر أعراض مختلفة في الطقس تعتبر من مسببات الربو أو تؤدي إلى نشاطه، مثل الغبار والأتربة وحبوب اللقاح والأسمدة، كما أن استخدام المبيدات ومواد التنظيف الكيميائية لطرد الحشرات يهيج الحساسية ويرهق الرئتين ويجعل التنفس صعبا.
الحساسية الموسمية
حساسية الربيع الموسمية من الأمراض الشائعة خلال هذا الفصل، وتعرف أيضا باسم حمى القش وتظهر مع بدء تغيّرات الجو التي تُنبئ بحلول فصل الربيع، فتتسبب الأتربة والغبار وحركة الأشجار وعملية التلقيح في حدوث حكة بالأنف وسيلان وعطس وحكة واحمرار في العينين.
فيروسات الجهاز التنفسي
لا يمكن أن يمر فصل الربيع أن تصاب بفيروس الإنفلونزا وتعاني مع الزكام بسبب التهابات الجهاز التنفسي والفيروسات التي قد تنشط خلال هذا الوقت من العام، فقد تمرض بإحدى نزلات البرد، وتتأثر الرئتان والحلق والجيوب الأنفية.
التهاب الملتحمة
تؤثر الأتربة وأجواء الطقس الربيعي التي قد تصبح حادة وعنيفة في بعض الأحيان على العين أيضا، فالحساسية وانتشار الفيروسات والبكتيريا قد يؤدي إلى التسبب في احمرار العين والشعور بألم كأن هناك شيئا عالق بها، كما يوضح موقع مايو كلينك، والرغبة في الحكة ونزول إفرازات من العين ويُعرف التهاب الملتحمة بالعين الوردية أو الرمد الربيعي.
ومن الشائع في الربيع، الإصابة بالتهاب المعدة والأمعاء نتيجة انتقال البكتيريا، أو التعرض للدغات الحشرات التي تسبب الحساسية.

أعراض أمراض الربيع
من الممكن أن تختلف أعراض أمراض الربيع وفقا لطبيعة كل مرض أو فيروس، ولكن في الغالب تتعلق الأمراض التي تنشط في هذا الفصل بالتحسس من الغبار والأتربة وأجواء الطقس الحادة، أو الإصابة بالفيروسات والعدوى البكتيرية التي يسهل انتشارها وتؤثر على الجهاز التنفسي والهضمي.
وأبرز هذه الأعراض:
- الحمى.
- الصداع.
- العطس.
- سيلان الأنف.
- التهاب الحلق.
- الطفح الجلدي.
- ضيق التنفس.
- احمرار العين والحكة.
- حكة في الأنف.
- السعال.
- الإرهاق والتعب الشديد.
- ألم في الصدر.
علاج أمراض الربيع
يمكن عند علاج أي من أمراض الربيع التي تم ذكرها أو أمراض أخرى الاعتماد على العلاجات المنزلية، ولكن مع تفاقم الأعراض واستمرارها من الأفضل الذهاب إلى الطبيب المختص، ومن العقاقير أو الطرق المنزلية التي يمكن الاعتماد عليها أولا، والتي قد تختلف وفقا لحالتك الصحية، وهي:
- مضدات الهستامين.
- قطرات العين
- بخاخات الأنف.
- حبوب السترويدات
- إبر الحساسية.
- تناول المشروبات العشبية التي تخفف من الحمى,
7 أمراض شائعة في الطقس البارد.. احذر قرحة البرد والصدفية ونوبات القلب
الوقاية من أمراض الربيع
أما للتعامل مع أمراض الربيع والوقاية من الإصابة بها، يمكن تجربة بعض الطرق المنزلية واتخاذ الاحتياطات التي تقي من العدوى، خاصة إذا كان لديك تاريخ مرضي يجعلك أكثر عرضة للإصابة بأمراض الجهاز التنفسي، ومن هذه الطرق:
- إغلاق النوافذ وعدم الخروج من المنزل عند هبوب الرياح والأتربة.
- بعد العودة من الخارج، يُفضل الاستحمام وتغيير الملابس وغسل الشعر للتخلص من أي عوالق قد تؤدي للعدوى.
- تناول أطعمة غنية بالفيتامينات التي تعمل على تقوية المناعة.
- استخدام غسول الأنف لتجنب الالتهابات.
نصائح للتعامل مع أمراض الربيع
يمكن التخفيف من حدة الأمراض الربيعية بالاعتماد على هذه النصائح:
- استخدام مرشحات هوائية داخل المنزل.
- الاستعداد إذا كنت من مرضى حساسية الأنف والصدر.
- المكوث في المنزل في أيام الطقس السيء.
- تنظيف المنزل باستمرار والتخلص من الغبار والأتربة.
- يُفضل استخدام التكييف في المنزل والسيارة.
لا داعي للقلق من أمراض الربيع الموسمية التي قد تزول باتباع النصائح وأساليب الوقاية اللازمة، ومرور هذا الفصل بسلام، ولكن يجب اللجوء للطبيب المختص في حال تفاقم الأعراض.